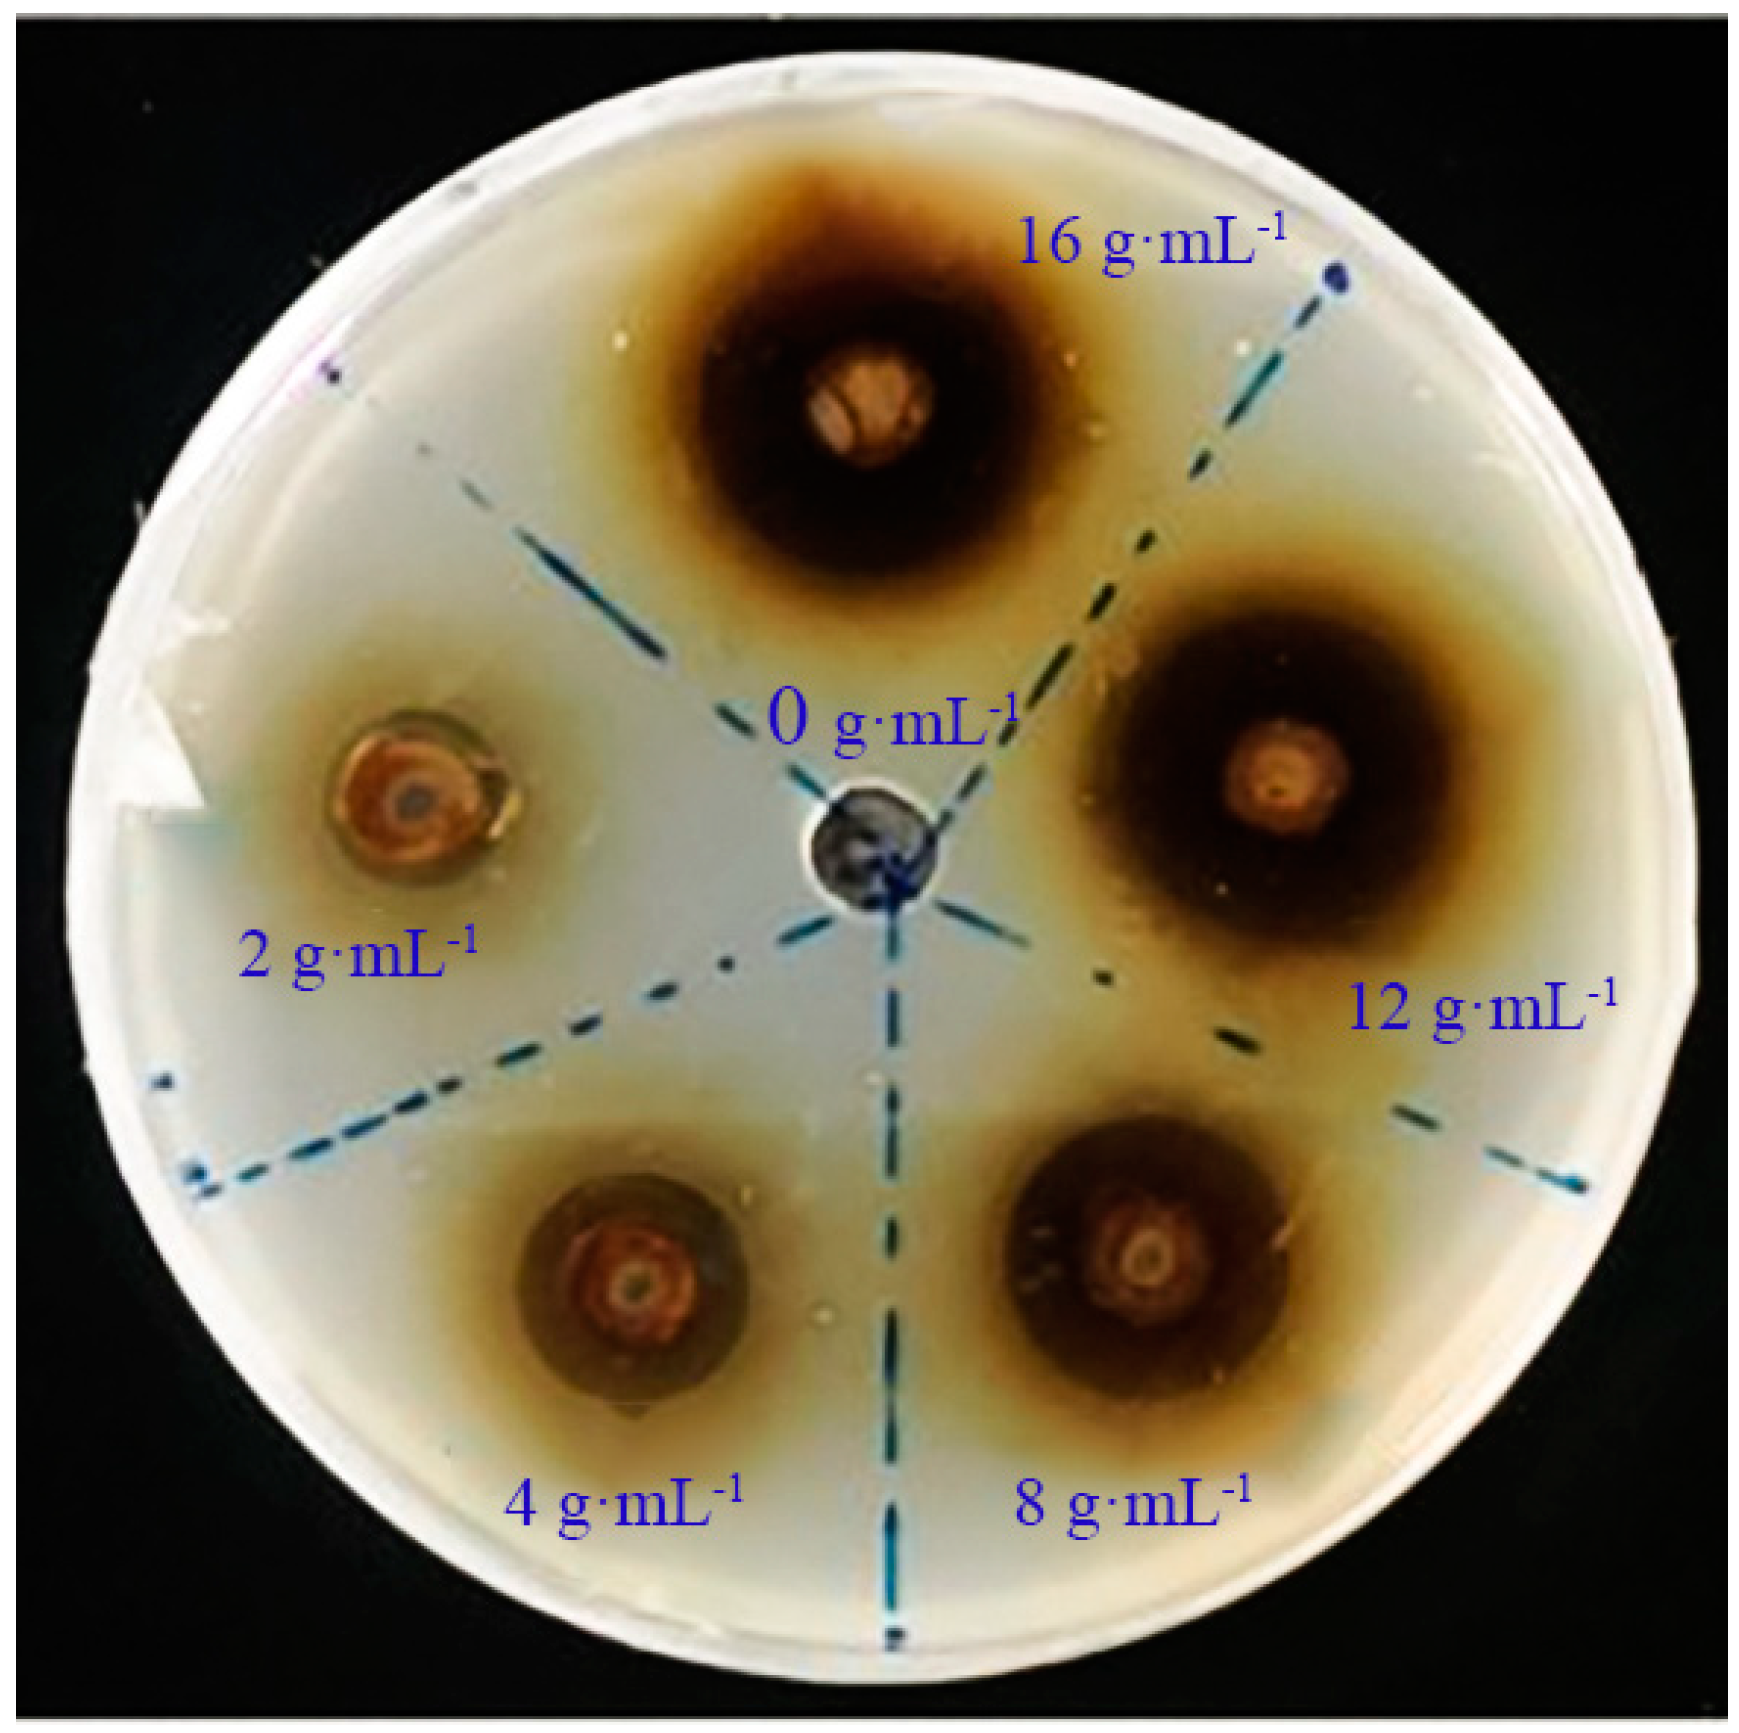

Bacteriostatic Activity and Resistance Mechanism of Artemisia annua Extract Against Ralstonia solanacearum in Pepper
Abstract
1. Introduction
2. Results
2.1. The Inhibitory Effect of A. annua Extract on R. solanacearum Activity
2.2. MIC Value
2.3. Inhibition Curve of A. annua Extract
2.4. The Effect of A. annua Extract on the Biofilm of R. solanacearum
2.5. The Effect of A. annua Extract on the Morphology of R. solanacearum
2.6. The Efficacy of A. annua Extract in Controlling Pepper Wilt Disease Caused by R. solanacearum
2.7. The Impact of A. annua Extract on the Content of Primary Metabolites in Pepper
2.8. The Impact of A. annua Extract on the Content of Defense System Substances in Pepper
2.8.1. The Effect of A. annua Extract on the MDA Content in Pepper
2.8.2. The Effect of A. annua Extract on the H2O2 Content in Pepper
2.8.3. The Effect of A. annua Extract on the Total Phenol Content in Pepper
2.8.4. The Effect of A. annua Extract on the Flavonoid Content in Pepper
2.9. The Effect of A. annua Extract on the Activity of Enzymes Related to the Pepper Defense System
3. Discussion
4. Materials and Methods
4.1. Materials
4.2. Preparation of the A. annua Extract
4.3. Determination of the Bacteriostatic Activity of A. annua Extract
4.3.1. Solid Plate Assay of A. annua Extract for Inhibiting R. solanacearum
4.3.2. The Determination of Minimum Inhibitory Concentration (MIC)
4.3.3. Measurement of Inhibition of R. solanacearum Growth
4.3.4. Measurement of Biofilm Formation by R. solanacearum
4.3.5. Morphological Measurement of R. solanacearum
4.4. Assessment of Disease Resistance in Pepper Plants After Treatment with A. annua Extract
4.4.1. Potted Plant Experiment and Sampling Method
4.4.2. Measurement of Control Efficacy Against Bacterial Wilt
4.4.3. Measurement of Primary Metabolite Content
4.4.4. Measurement of Defense Substance Content
- (1)
- Measurement of MDA Content
- (2)
- Measurement of H2O2 Content
- (3)
- Measurement of total phenol content
- (4)
- Measurement of flavonoid content
4.4.5. Measurement of Defense-Related Enzyme Activities
4.5. Data Analysis
5. Conclusions
Author Contributions
Funding
Data Availability Statement
Acknowledgments
Conflicts of Interest
References
- Zou, X.X.; Ma, Y.Q.; Dai, X.Z.; Li, X.F.; Yang, S. Spread and Industry Development of Pepper in China. Acta Hort. Sin. 2020, 47, 1715–1726. [Google Scholar]
- Wang, L.H.; Zhang, B.X.; Zhang, Z.H.; Cao, Y.C.; Yu, H.L.; Feng, X.G. Status in breeding and production of Capsicum spp. in China during ‘the thirteenth five-year plan’ period and future prospect. China Veg. 2021, 2, 21–29. [Google Scholar]
- Mohammed, A.F.; Oloyede, A.; Odeseye, A. Biological control of bacterial wilt of tomato caused by Ralstonia solanacearum using pseudomonas species isolated from the rhizosphere of tomato plants. Arch. Phytopathol. Plant Prot. 2020, 53, 1–4. [Google Scholar] [CrossRef]
- Wang, J.; Long, S.F.; Wang, Z.W.; Chen, J.W.; Jiang, F.Y.; Li, X. Research progress in controlling tomato bacterial wilt. China Veg. 2020, 1, 22–30. [Google Scholar]
- Jose, J.; Éva, C.; Bozsó, Z.; Hamow, K.A.; Fekete, Z.; Fábián, A.; Bánfalvi, Z.; Sági, L. Global transcriptome and targeted metabolite analyses of roots reveal different defence mechanisms against Ralstonia solanacearum infection in two resistant potato cultivars. Front. Plant. Sci. 2023, 13, 1065419. [Google Scholar] [CrossRef] [PubMed]
- Huang, Z.C.; Liu, Y.; Zeng, F.H.; Lu, X.Y. Advances in pathogenesis of Ralstonia solanacearum and crops resistance to bacterial wilt. J. Trop. Subtrop. Bot. 2008, 5, 491–496. [Google Scholar]
- Nion, Y.A.; Toyota, K. Recent trends in control methods for bacterial wilt diseases caused by Ralstonia Solanacearum. Microbes. Environ. 2015, 30, 1–11. [Google Scholar]
- Ahmed, W.; Yang, J.; Tan, Y.; Munir, S.; Liu, Q.; Zhang, J.; Ji, G.; Zhao, Z. Ralstonia solanacearum, a deadly pathogen: Revisiting the bacterial wilt biocontrol practices in tobacco and other solanaceae. Rhizosphere 2022, 21, 100479. [Google Scholar] [CrossRef]
- Li, P.; Yang, Z.; Tang, B.; Zhang, Q.; Yan, J. Identification of xanthones from the mangosteen pericarp that inhibit the growth of Ralstonia solanacearum. ACS Omega 2019, 5, 334–343. [Google Scholar] [CrossRef] [PubMed]
- Yang, L.; Wang, Y.; He, X.; Xiao, Q.; Ding, W. Discovery of a novel plant-derived agent against Ralstonia solanacearum by targeting the bacterial division protein FtsZ. Pestic. Biochem. Phys. 2021, 177, 104892. [Google Scholar] [CrossRef] [PubMed]
- Han, S.; Yang, L.; Wang, Y.; Ran, Y.; Ding, W. Preliminary studies on the antibacterial mechanism of a new plant-derived compound, 7-methoxycoumarin, against Ralstonia solanacearum. Front. Microbiol. 2021, 12, 697911. [Google Scholar] [CrossRef] [PubMed]
- Wang, Y.J.; Geng, Y.X.; Gao, Y.Q.; Wang, J.H.; Feng, J.T.; Zhou, Y.W.; Lei, P.; Ma, Z.Q. Control effect of eight botanical pesticides against Zanthoxylum bungeanum aphids in field. J. Northwest AF Univ. 2022, 8, 88–93,102. [Google Scholar]
- Zhang, H.J.; Tao, L.M.; Liu, X.; Huang, X.Z. Review on registration and management of bio-pesticide in China. Chin. J. Biol. Control. 2022, 38, 9–17. [Google Scholar]
- Li, H.B.; Qin, D.P.; Ge, W.; Wang, Z.Z.; Cao, L.; Xiao, W.; Yu, Y.; Yao, X.S. Research progress on chemical constituents of Artemisia annua and its pharmacological activities. Chin. Tradit. Herb. Drugs 2019, 50, 3461–3470. [Google Scholar]
- Anibogwu, R.; Jesus, K.D.; Pradhan, S.; Pashikanti, S.; Mateen, S.; Sharma, K. Extraction, isolation and characterization of bioactive compounds from artemisia and their biological significance: A review. Molecules 2021, 26, 6995. [Google Scholar] [CrossRef] [PubMed]
- Zhao, Y.Q.; Yuan, Y. Biological and chemical synthesis of high-value active ingredients in traditional chinese medicine. China J. Chin. Mater. Medica 2024, 49, 3986–3997. [Google Scholar]
- Zhang, K.Y.; Fu, C.Q.; Ma, L.; Wang, M.Y.; Qiu, F. research advances of biosynthesis, in vivo analysis and pharmacokinetics of chemical constituents in Artemisiae Annuae Herba. China J. Chin. Mater. Medica 2021, 46, 347–358. [Google Scholar]
- Ning, R.; Li, Y.Q.; Wang, J.M.; Ji, M.S.; Shi, J.Q. Antibacterial activity of crude extract of Artemisia annua. Jiangsu Agric. Sci. 2007, 3, 61–63. [Google Scholar]
- Zheng, H.W.; Li, Z.Y.; Yang, F.; Zhang, W.Y. Study on selection, compatibility and antibacterial effect of Chinese medicine herbs against tomato late blight pathogen. Storage Process 2019, 19, 54–61. [Google Scholar]
- Wang, J.; Sun, J.H.; Zhang, X.C.; Gao, Z.Y.; Wang, J.B. Fungal inhibitory activity of the extracts of six plants against Peronophythora litchi. Genom. Appl. Biol. 2016, 35, 1219–1223. [Google Scholar]
- Wu, S.X.; Gao, F.Y.; Zhang, R.P.; Su, H.; Yao, H.Y.; Fan, X.L.; Li, Y.Y. Research progress in biological control of tomato bacterial wilt. Chin. J. Appl. Ecol. 2023, 34, 2585–2592. [Google Scholar]
- Fang, X.Y.; Yu, T.B.; Yang, L.; Zang, H.D.; Zeng, Z.H.; Yang, Y.D. Research progress of bacterial wilt and its soil micro-ecological regulation in peanut. Chin. J. Eco-Agric. 2023, 31, 1695–1707. [Google Scholar]
- Li, S.B.; Geng, R.M.; Xiao, Z.L.; Liu, Z.W.; Ren, M.; Feng, Q.F. Research progresses on breeding for resistance to bacterial wilt of tobacco (Nicotiana tabacum L.). Mol. Plant Breed. 2014, 1–11. Available online: https://kns.cnki.net/kcms/detail/46.1068.S.20230315.1541.004.html (accessed on 22 January 2025).
- Hu, C.C.; Zhou, D.H.; Chen, X.W.; Zhong, J.L.; Mao, C.Q. Efficacies and mechanisms of a formula of chinese medicinal plants (MHC-20) against streptococcus pyogenes. China Surfactant Deterg. Cosmet. 2024, 54, 282–289. [Google Scholar]
- Tong, T.T.; Ji, X.W.; Liao, S.Q.; Fu, J.E.; Xia, X.H. Discussion on the multi-residue detection method for banned pesticides in Chinese Pharmacopoeia (2020 edition) based on LC-MS/MS. Agrochemicals 2024, 63, 196–203. [Google Scholar]
- Gendrot, M.; Duflot, I.; Boxberger, M.; Delandre, O.; Jardot, P.; Le Bideau, M.; Andreani, J.; Fonta, I.; Mosnier, J.; Rolland, C.; et al. Antimalarial artemisinin-based combination therapies (act) and covid-19 in africa: In vitro inhibition of SARS-cov-2 replication by mefloquine-artesunate. Int. J. Infect. Dis. 2020, 99, 437–440. [Google Scholar] [CrossRef] [PubMed]
- Luo, J.; Zhang, Y.; Wang, Y.; Liu, Q.; Li, J.; He, H.; Luo, Y.; Huang, S.; Guo, X. Artesunate and dihydroartemisinin inhibit rabies virus replication. Virol. Sin. 2021, 36, 721–729. [Google Scholar] [CrossRef] [PubMed]
- Ma, D.Y.; Ji, D.C.; Zhang, Z.Q.; Li, B.D.; Qin, G.Z.; Xu, Y.; Chen, T.; Tian, S.P. Efficacy of rapamycin in modulating autophagic activity of botrytis cinerea for controlling gray mold. Postharvest Biol. Technol. 2019, 150, 158–165. [Google Scholar] [CrossRef]
- Bordean, M.E.; Ungur, R.A.; Toc, D.A.; Borda, I.M.; Martis, G.S.; Pop, C.R.; Filip, M.; Vlassa, M.; Nasui, B.A.; Pop, A.; et al. Antibacterial and phytochemical screening of artemisia species. Antioxidans 2023, 12, 596. [Google Scholar] [CrossRef]
- Niu, Y.; Fu, S.; Chen, G.; Wang, H.; Wang, Y.; Hu, J.X.; Jin, X.; Zhang, M.; Lu, M.; He, Y. Different epitopes of Ralstonia solanacearum effector RipAW are recognized by two Nicotiana species and trigger immune responses. Mol. Plant. Pathol. 2022, 23, 188–203. [Google Scholar] [CrossRef] [PubMed]
- Kumar, S.; Ahmad, K.; Behera, S.K.; Nagrale, D.T.; Chaurasia, A.; Yadav, M.K.; Murmu, S.; Jha, Y.; Rajawat, M.V.S.; Malviya, D.; et al. Biocomputational assessment of natural compounds as a potent inhibitor to quorum sensors in Ralstonia solanacearum. Molecules 2022, 27, 3034. [Google Scholar] [CrossRef]
- Chattopadhyay, P.; Banerjee, G.; Handique, P.J. Use of an abscisic acid-producing bradyrhizobium japonicum isolate as biocontrol agent against bacterial wilt disease caused by Ralstonia solanacearum. J. Plant. Dis. Protect. 2022, 129, 869–879. [Google Scholar] [CrossRef]
- Shi, H.C.; Wang, S.Y.; Liu, M.Y.; Deng, J.y.; Zhao, W.G.; LI, P.; Wu, F. Identification of mulberry root exudates and effects of main active compounds on the growth of Ralstonia pseudosolanacearum. Plant Physiol. J. 2024, 60, 1475–1485. [Google Scholar]
- Zhang, H.; Lin, Z.J.; Zhu, J.D.; Lin, Z.M.; Li, G.L.; Xu, Y.Q.; Liu, Z.H.; Qiu, Y.X.; Qiu, S.X. Uridine diphosphate-glucose 4-epimerase encoding gene galE affects the pathogenicity and carbon metabolism of Ralstonia pseudosolanacearum. J. Zhejiang Univ. Agric. Life Sci. 2023, 49, 662–676. [Google Scholar]
- Yang, L.; Wei, Z.; Li, S.; Xiao, R.; Xu, Q.; Ran, Y.; Ding, W. Plant secondary metabolite, daphnetin reduces extracellular polysaccharides production and virulence factors of Ralstonia solanacearum. Pestic. Biochem. Phys. 2021, 179, 104948. [Google Scholar] [CrossRef] [PubMed]
- Xia, H.; Huang, Y.; Wu, R.; Tang, X.; Cai, J.; Li, S.; Jiang, L.; Wu, D. A screening identifies harmine as a novel antibacterial compound against Ralstonia solanacearum. Front. Microbiol. 2023, 14, 1269567. [Google Scholar] [CrossRef] [PubMed]
- Yousefvand, M.; Harighi, B.; Azizi, A. Volatile compounds produced by endophytic bacteria adversely affect the virulence traits of Ralstonia solanacearum. Biol. Control. 2023, 178, 105145. [Google Scholar] [CrossRef]
- Wang, J.; Peng, Y.; Xie, S.; Yu, X.; Bian, C.; Wu, H.; Wang, Y.; Ding, T. Biocontrol and molecular characterization of Bacillus velezensisd D against tobacco bacterial wilt. Phytopathol. Res. 2023, 5, 50. [Google Scholar] [CrossRef]
- Raza, A.; Salehi, H.; Rahman, M.A.; Zahid, Z.; Madadkar Haghjou, M.; Najafi-Kakavand, S.; Charagh, S.; Osman, H.S.; Albaqami, M.; Zhuang, Y.; et al. Plant hormones and neurotransmitter interactions mediate antioxidant defenses under induced oxidative stress in plants. Front. Plant. Sci. 2022, 13, 961872. [Google Scholar] [CrossRef]
- Neilson, E.H.; Goodger, J.Q.; Woodrow, I.E.; Møller, B.L. Plant chemical defense: At what cost? Trends. Plant. Sci. 2013, 18, 23415056. [Google Scholar] [CrossRef]
- Zaynab, M.; Fatima, M.; Sharif, Y.; Zafar, M.H.; Khan, K.A. Role of primary metabolites in plant defense against pathogens. Microb. Pathog. 2019, 137, 103728. [Google Scholar] [CrossRef]
- Sheng, J.P.; Zhao, R.R.; Chen, L.L.; Shen, L. Effect of pre-harvest melatonin spraying on the post-harvest disease resistance and storage quality of tomato fruit. Food Sci. 2020, 41, 188–193. [Google Scholar]
- Wang, F.; Xiao, Y.; Mi, J.X.; Shi, Y.J.; Wan, X.Q.; Yang, H.B. physiological and biochemical responses of different resistant walnuts to brown spot infection by Ophiognomonia leptostyla. Acta Bot. Boreal-Occident. Sin. 2022, 42, 2083–2092. [Google Scholar]
- Sies, H.; Jones, D.P. Reactive oxygen species (ROS) as pleiotropic physiological signalling agents. Nat. Rev. Mol. Cell Biol. 2020, 21, 363–383. [Google Scholar] [CrossRef] [PubMed]
- Rajput, V.D.; Harish Singh, R.K.; Verma, K.K.; Sharma, L.; Quiroz-Figueroa, F.R.; Meena, M.; Gour, V.S.; Minkina, T.; Sushkova, S.; Mandzhieva, S. Recent developments in enzymatic antioxidant defence mechanism in plants with special reference to abiotic stress. Biology 2021, 10, 267. [Google Scholar] [CrossRef] [PubMed]
- Baker, A.; Lin, C.; Lett, C.; Karpinska, B.; Wright, M.H.; Foyer, C.H. Catalase: A critical node in the regulation of cell fate. Free Radic. Biol. Med. 2023, 199, 56–66. [Google Scholar] [CrossRef] [PubMed]
- Ahammed, G.J.; Li, Z.; Chen, J.; Dong, Y.; Qu, K.; Guo, T.; Wang, F.; Liu, A.; Chen, S.; Li, X. Reactive oxygen species signaling in melatonin-mediated plant stress response. Plant Physiol. Biochem. 2024, 207, 108–398. [Google Scholar] [CrossRef] [PubMed]
- Wang, P.; Liu, W.C.; Han, C.; Wang, S.; Bai, M.Y.; Song, C.P. Reactive oxygen species: Multidimensional regulators of plant adaptation to abiotic stress and development. J. Integr. Plant Biol. 2024, 3, 14. [Google Scholar] [CrossRef] [PubMed]
- Sun, Y.Q.; Gui, Z.Q.; Sun, F.F.; Han, X.; Zong, H.; Du, Y.M. Effect and mechanism of cis-abienol to induce tobacco against bacterial wilt. Chin. Tobacco Sci. 2023, 44, 66–73. [Google Scholar]
- Zhang, J.; Sun, X. Recent advances in polyphenol oxidase-mediated plant stress responses. Phytochemistry 2021, 181, 112588. [Google Scholar] [CrossRef] [PubMed]
- Dong, N.Q.; Lin, H.X. Contribution of phenylpropanoid metabolism to plant development and plant–environment interactions. J. Integr. Plant Biol. 2021, 63, 180–209. [Google Scholar] [CrossRef] [PubMed]
- Zhang, X.; Li, J.; Feng, L.D.; He, J.; Li, Y.H.; Sun, T.; Zhang, S.D. Effects of three disease resistance inducers on leaf growth, disease resistance and related enzyme activities of Lycium barbarum. J. Yunnan Agric. Univ. Nat. Sci. 2022, 37, 413–421. [Google Scholar]
- Li, J.; Li, X.H.; Li, L.A.; Zhang, Y.Q.; Kang, J.; Huang, J.B.; Zheng, L.; Li, Y.Y. Screening of compound plant elicitors and the synergistic mechanism for controlling tobacco bacterial wilt. J. South. Agric. 2023, 54, 2257–2268. [Google Scholar]
- Yu, F.; Li, J.; Li, Y.Y.; Li, X.H.; Zheng, L.; Peng, W.X.; Huang, J.B. Study on the effect of hesperetin on the induction of tobacco resistance to bacterial wilt. Chin. Tob. Sci. 2022, 43, 55–61. [Google Scholar]
- Li, D.Q.; Qian, Y.M.; Zhou, M.M.; Tan, R.; Deng, Z.F.; Yuan, S.X. The mechanism of biological control of strawberry gray mould using the marine bacterial NH-8 strain and analysis of the antifungal substances from the strain. J. Plant Prot. 2016, 43, 215–221. [Google Scholar]
- Huo, X.W.; Shuang, S.; Li, J.W.; Zhang, Y.; Li, Y.L.; Fu, Q.W.; Zhang, Z.Q. Odontothrips loti feeding behavior and its impact on alfalfa defense enzyme activity and encoding gene expression. Chin. J. Grassl. 2024, 46, 34–42. [Google Scholar]
- Jin, C.Y.; Xie, Q.L.; Peng, F.; Wang, X.P.; Yang, Y.D. Extraction and activity ealuation of the pant pathogenic fungi inhibition compounds from chestnut flower. J. Nucl. Agric. Sci. 2024, 38, 889–898. [Google Scholar]
- Guo, Y.T.; Zheng, H.R.; Zhang, Y.; Wu, Q.Q.; Zhu, Y.H.; Zhang, X.X.; Zhang, J.Y. Recent research progress on chemical components and pharmacological activities of Artemisia annua L. Northwest Pharm. J. 2023, 38, 241–249. [Google Scholar]
- Zhang, Q. Study on the Endophytes in Portulaca oleracea L. Against Bacterial Wilt; South China Agricultural University: Guangzhou, China, 2019. [Google Scholar]
- Li, F.; Chen, W.W.; Deng, J.L.; Mao, Q.L.; Quan, W.L.; Mao, Y.H. Inhibitory effect of resveratrol on walnut bacterial black spot pathogen. Biotechnol. Bull. 2021, 37, 58–65. [Google Scholar]
- Zhou, Q.q.; Yang, Q.L.; Li, Y.; Li, Y.H.; Yang, D.C.; Wu, Z.L. Novel fluoroquinolone derivatives inhibit growth and biofilm formation of pathogenic bacteria in aquatic animals. Acta Microbiol. Sin. 2023, 63, 3041–3053. [Google Scholar]
- Liu, Y.X.; Jiang, F.; Zhang, N.; Wang, H.T.; Ai, X.Z. Relationship between osmoregulation and bacterial wilt resistance of grafted pepper. Acta Hortic. Sin. 2011, 38, 903–910. [Google Scholar]
- Chow, P.S.; Landhausser, S.M. A method for routine measurements of total sugar and starch content in woody plant tissues. Tree Physiol. 2004, 24, 1129–1136. [Google Scholar] [CrossRef] [PubMed]
- Pierce, J.; Suelter, C.H. An evaluation of the Coomassie brilliant blue G-250 dye-binding method for quantitative protein determination. Anal. Biochem. 1977, 81, 478–480. [Google Scholar] [CrossRef] [PubMed]
- Friedman, M. Applications of the ninhydrin reaction for analysis of amino acids, peptides, and proteins to agricultural and biomedical sciences. J. Agric. Food Chem. 2004, 52, 385–406. [Google Scholar] [CrossRef] [PubMed]
- Feng, Y.j.; Wang, X.Y.; Du, T.T.; Shu, Y.H.; Tan, F.X.; Wang, J.W. Effects of salicylic acid concentration and post-treatment time on the direct and systemic chemical defense responses in Maize (Zea mays L.) following exogenous foliar application. Molecules 2022, 27, 6917. [Google Scholar] [CrossRef]
- Liu, F.Y.; Yang, Y.; Jia, W.; Zhang, J.S.; Tang, C.H. The study on the determination method of total flavonoids in the medicinal fungus Phellinus linteus. Acta Edulis Fungi 2006, 13, 45–48. [Google Scholar]

| Concentration (g·mL−1) | Diameter of Inhibition Zone (mm) | Inhibition Zone | Virulence Regression Equation | EC50 Value |
|---|---|---|---|---|
| 0 | 0 | − | ||
| 2 | 4.07 ± 0.09 e | + | y = 0.7551x + 4.6811 R2 = 0.9856 | 2.66 g·mL−1 |
| 4 | 6.71 ± 0.05 d | + | ||
| 8 | 9.21 ± 0.16 c | + | ||
| 12 | 6.71 ± 0.05 d | ++ | ||
| 16 | 12.62 ± 0.16 a | ++ |
| Concentration (g·mL−1) | Phenomenon |
|---|---|
| 0.19 | + |
| 0.38 | + |
| 0.75 | + |
| 1.5 | + |
| 3 | − |
| 6 | − |
Disclaimer/Publisher’s Note: The statements, opinions and data contained in all publications are solely those of the individual author(s) and contributor(s) and not of MDPI and/or the editor(s). MDPI and/or the editor(s) disclaim responsibility for any injury to people or property resulting from any ideas, methods, instructions or products referred to in the content. |
© 2025 by the authors. Licensee MDPI, Basel, Switzerland. This article is an open access article distributed under the terms and conditions of the Creative Commons Attribution (CC BY) license (https://creativecommons.org/licenses/by/4.0/).
Share and Cite
Du, T.; Zhu, W.; Zhang, C.; Liang, X.; Shu, Y.; Zhou, J.; Zhang, M.; He, Y.; Tu, J.; Feng, Y. Bacteriostatic Activity and Resistance Mechanism of Artemisia annua Extract Against Ralstonia solanacearum in Pepper. Plants 2025, 14, 651. https://doi.org/10.3390/plants14050651
Du T, Zhu W, Zhang C, Liang X, Shu Y, Zhou J, Zhang M, He Y, Tu J, Feng Y. Bacteriostatic Activity and Resistance Mechanism of Artemisia annua Extract Against Ralstonia solanacearum in Pepper. Plants. 2025; 14(5):651. https://doi.org/10.3390/plants14050651
Chicago/Turabian StyleDu, Tiantian, Weiping Zhu, Chenning Zhang, Xiaomin Liang, Yinghua Shu, Jingyun Zhou, Mengyu Zhang, Yuxuan He, Jincai Tu, and Yuanjiao Feng. 2025. "Bacteriostatic Activity and Resistance Mechanism of Artemisia annua Extract Against Ralstonia solanacearum in Pepper" Plants 14, no. 5: 651. https://doi.org/10.3390/plants14050651
APA StyleDu, T., Zhu, W., Zhang, C., Liang, X., Shu, Y., Zhou, J., Zhang, M., He, Y., Tu, J., & Feng, Y. (2025). Bacteriostatic Activity and Resistance Mechanism of Artemisia annua Extract Against Ralstonia solanacearum in Pepper. Plants, 14(5), 651. https://doi.org/10.3390/plants14050651

